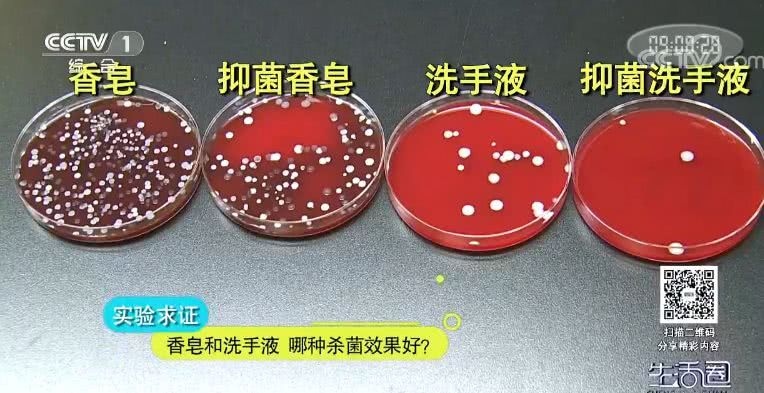

圈友求助
勤洗手是坚持个人健康的杰出习气,也是防备疾病传达最好的办法之一。最近,有圈友关于洗手用品的挑选提出了疑问。
圈友“一个李子”:现在无论是在家里仍是在公共场所,洗手液是最常见的。不过也有许多白叟仍是会挑选用香皂洗手。那么这两种洗刷用品在清洁方面有没有差异呢?用哪种洗手更好呢?
一个试验
为了一探终究,小圈购买了四种洗手用品,别离是一般香皂、带有抑菌功用的香皂,一般洗手液以及带有抑菌功用的洗手液。
试验员将事前调制好的大肠杆菌培养液,等量地涂改在四位测验者的手掌内侧。涂改均匀之后,试验员别离对四位测验者手掌上的大肠杆菌进行取样。接下来,咱们请四位测验者别离挑选四种洗手用品中的一种,用规范的“六步洗方法”清洗手上的大肠杆菌。
等四位测验者洗完之后,试验员再次对测验者手上的大肠杆菌进行取样。最终试验员将一切样品放入到恒温箱中,等候48小时。
成果显现,用一般香皂洗手之后,手上残留的大肠杆菌数量最多。排在第二位的是带有抑菌功用的香皂。第三位则是一般洗手液。而大肠杆菌残留最少的是带有抑菌功用的洗手液。
在灭菌方面,带有抑菌功用的香皂要比一般香皂好,而洗手液也是如此。
熊金平
北京化工大学教授
无论是香皂或者是洗手液,假如它标明具有灭菌作用,通常状况下必定要加灭菌剂,加灭菌剂的状况下面必定比不加灭菌剂的灭菌作用强。
这是不是阐明在灭菌方面,洗手液要比香皂更好呢?
等风来
洗手液之所以会比香皂的灭菌作用好,是因为它们所含的表面活性剂品种不同,洗手液中含有的两性表面活性剂在灭菌才能方面更好一些。
别的,两性表面活性剂的去污才能也比阴离子表面活性剂要强一些。不过尽管如此,两性表面活性剂也有自己的缺陷,那就是简单残留在手上。许多人在用洗手液洗手的时分都会有一种感触,那就是洗完之后,尽管看不到泡沫了,但总感觉手上黏乎乎的,如同没洗洁净相同,而现实上这正是洗手液在手上残留的体现。
主张咱们在用洗手液洗手时,应当重复屡次冲刷,并经过双手冲突的办法来判别是否冲刷洁净。
香皂长时间露出在空气中,并且处在湿润环境,很简单繁衍细菌并且多人运用简单穿插感染,现实真的是这样吗?
柴宝宝
香皂比洗手液更易繁衍细菌。
香皂放在一个露出的空间,然后在清洗的过程中,脏的手会重复地去擦香皂,然后手上的细菌会留在香皂上,即便你拿流水去清洗,也会保存必定细菌,然后它又处在一个湿润的环境下,有必定温度、湿度,细菌就简单在上边繁衍,特别是长时间运用的香皂上,都会沾有许多细菌。
而洗手液它本身在一个瓶子里,手上的细菌进不到瓶子里,所以它不会污染瓶子,并且环境中的细菌也进不到瓶子里,不会污染洗手液,那么洗手液里就不会有许多外来的细菌,从细菌繁衍和穿插感染的视点来说,洗手液要显着优于香皂。
从维护皮肤的视点来说,香皂和洗手液哪种对皮肤损害更小呢?
请输入
咱们洗完手今后皮肤简单发白,实际上干裂了,皮肤没有油脂了,才会体现出皮肤很粗糙,毫无疑问的洗手液比香皂要来得凶猛得多。
小贴士
总的来说,洗手液在灭菌方面和去污才能上比香皂更强一些,运用起来比较便利,不简单穿插感染,可是清洗不细心的话简单残留在手上。
关于香皂而言,它的优势在于洗完手之后不简单残留,并且对皮肤的损害相对较小。而价格方面,香皂和洗手液相差并不太大,您能够依据自己的实际状况进行挑选。
假如选用香皂的话,需求留意最好不要和他人共用,一起定时清洗、替换皂盒,不必的时分坚持皂盒和皂体枯燥,以避免穿插感染。假如是需求共用,最好仍是挑选洗手液。
当然,无论是运用香皂仍是洗手液,养成杰出的、及时洗手的习气,才是更重要的。

重庆丰益中医肛肠医院看病贵不贵?收费透明,看病不贵
校园直击!紫竹蜂胶口腔膜治愈风潮燃动福州!
万众瞩目:络病大会召开 微血管病变防治开辟新局面
毓婷x学院奖云课堂完美收官|“毓”青春同行,创意步履不“婷”
发现就是中晚期的结直肠癌,其实有办法可以避免!
“毓”见别YOUNG青春——毓婷携手学院奖2022再启新程
成都中德肾病医院付冬梅--专业经验技术 让你放心无忧
成都中德肾病医院专家韩艳简介